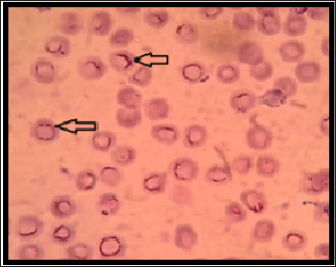
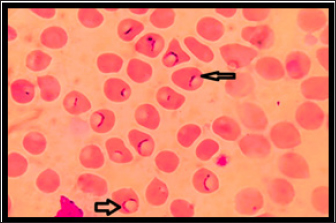

| Research Article | ||
Open Vet. J.. 2024; 14(12): 3417-3427 Open Veterinary Journal, (2024), Vol. 14(12): 3417-3427 Research Article Molecular study and phylogenetic analysis of hemotropic Mycoplasma in Baghdad province, IraqDunya Zeyad Saeed and Naseir Mohammed Badawi*Department of Internal and Preventive Veterinary Medicine, College of Veterinary Medicine, University of Baghdad, Baghdad, Iraq *Corresponding Author: Naseir Mohammed Badawi. Department of Internal and Preventive Veterinary Medicine, College of Veterinary Medicine, University of Baghdad, Baghdad, Iraq. Email: naseir.m [at] covm.uobaghdad.edu.iq, naseir.badawi78 [at] gmail.com Submitted: 30/09/2024 Accepted: 04/11/2024 Published: 31/12/2024 © 2024 Open Veterinary Journal
AbstractBackground: Hemotrophic Mycoplasmas (HMs) are uncultivable, pleomorphic, very small epicellular, and like other Mycoplasma species lacking a cell wall. These pathogens damage and alter the erythrocytes by invading or parasitizing their surface, which can lead to persistent infections and complications. The most common HMs species in dogs are Candidatus Mycoplasmas haematoparvum (CMhp), and Mycoplasma haemocanis (Mhc). Aim: The study aimed to detect infectious rates of hemotrophic Mycoplasma infections in dogs by molecular assay from Baghdad province for the first time. Methods: The study included 155 dogs consisting vary breeds, ages, and both sexes from October 2023 to March 2024. The target gene for identified HMs in dogs was the 16s rRNA gene, where used two primers to amplify a fragment of approximately 618 bp of the target gene. Results: The PCR results indicated a 618 bp band of positive 16s rRNA gene of HMs. Six out of 155 dogs tested were positive by PCR, producing a 4% infection rate of HMs in dogs in Baghdad/Iraq (2% of each CMhp and uncultured Mycoplasma spp.), which had 100% matching with Mhc based on the 16S rRNA sequences. The highest infection rates were reported non-significantly in January in dogs older than 1 year, males, and significantly in the Malinois dogs. The main hematological values exhibited significant changes in the mean corpuscular hemoglobin concentration, RDW, and PDWS; also, normocytic normochromic and microcytic normochromic anemia were observed in two dogs infected with hemotropic mycoplasmosis. The phylogenetic analysis revealed that sequence alignment on the NCBI-BLAST site had a high identity with M. hacmocanis recorded by NCBI uncultured Mycoplasma spp. and candidatus Mycoplasma hemtoparvum. The relationship between geographical regions and uncultured Mycoplasma spp. and CMhp of the present study in the phylogenic trees revealed that sequences were grouped in the same branch of the several countries in the phylogenic tree, especially neighboring countries (Iran and Turkey). Conclusion: This study is the first molecularly and phylogenetically detected of hemotropic Mycoplasma in Baghdad/Iraq. The results of phylogenetic analysis indicated that there was no specific substitution of sequences or genetic diversity of the hemotropic Mycoplasma in dogs from Iraq with other countries. Keywords: Molecular, Dogs, Hemotrophic, Mycoplasmas, Baghdad. IntroductionHemotrophic Mycoplasmas (HMs) are uncultivable, pleomorphic, very small epicellular, and like other Mycoplasma species lacking a cell wall. These pathogens damage and alter the erythrocytes by invading or parasitizing their surface, which can lead to persistent infections and complications (Arendt et al., 2024). HMs are small in size, about less than 1 μm, and directly adhered to the red blood cell (RBC) surfaces of the infected animals (Willi et al., 2010). The most common HMs species in dogs are Candidatus Mycoplasmas haematoparvum (CMhp), and Mycoplasma haemocanis (Mhc) (Roblejo-Arias et al., 2022), and rarely Mycoplasma haemominutum (Zheng et al., 2017). In Turkey, Mhc and CMhp were identified according to molecular assays of 8.24% and 10.82%, respectively. CMhp, not Mhc, has the potential to infect humans. This study is the first molecular investigation on hemoplasmas in dogs from Sivas Province/Turkey (Erol et al., 2021). One study in India revealed the presence of Mycoplasmas at the erythrocyte surface in 2.75% out of 1235 dogs. This study discovered the high incidence of HMs in young and male dogs, which may be related to their increased exposure to tick vectors. Furthermore, the climate temperature and housing conditions were casually associated with an increased risk of hemoplasma infection (Preena et al., 2020). Some countries in Europe reported previously high prevalence of HMs, particularly in Mediterranean climates (Willi et al., 2010). The transmission of HMs can occur through transplacenta, blood transfusions, animals fighting, and contaminated fomites. The major route of transmission, especially to M. haemocanis by Rhipicephalus sanguineus ticks (Ravagnan et al., 2017). Rhipicephalus sanguineus was a high prevalence in dogs from Iraq/Baghdad (Fadhil, 2014). The review identified several mechanisms that contribute to the pathogenicity of these HMs. These organisms damage the cell membrane by generating free radicals. Furthermore, the HMs breakdown of the cell membrane results in an insufficient supply of nutrients or biosynthetic precursors for the cells. Sometimes, HMs damage induces autoantibodies, which disrupt the immune response and lead to autoimmune hemolytic anemia (Mazaheri et al., 2014). Many of the clinical symptoms cited with HMs in animals, including lethargy, weakness, collapse, pallor, depression, dyspnea/tachypnea, tachycardia, cardiac sound “murmur,” lymphadenopathy, hepatosplenomegaly, fever, dehydration, icterus, weight loss, and pica, result from immune-mediated anemia, which can lead to death in severe cases (Barker, 2019). Hematological changes in HMs infection revealed neutropenia, thrombocytopenia, lymphocytosis, and monocytosis when compared to the clinically healthy dog (Preena et al., 2020). A study in Basra province of Iraq by Radhi and Wadood Alsaad (2022) reported a 72% infection rate of Mhc, whereas the infection rate was 45.8% according to conventional PCR and confirmed the diagnosis by sequencing for three samples under accession numbers (MW784616.1, MW784617.1, and MW784618.1). This study revealed a significant decrease in RBC count, PCV, mean corpuscular hemoglobin (MCH), mean corpuscular hemoglobin concentration (MCHC), and hemoglobin concentration compared with healthy dogs, as well as a significant increase in mean corpuscular volume (MCV), and leukocytosis (Radhi and Wadood Alsaad, 2022). Mycoplasma hacmocanis was microscopically diagnosed in dogs from Basra province/Iraq in 20 domesticated dogs (Jarad and Abed, 2020). The diagnosis of the HMs is mainly based on the molecular identification and sequences of the 16S rRNA genes (Wang et al., 2017), 2017. In 2002, the investigation of the RNase P genes of HMs and their sequences revealed 94.3 to 95.5% identity (Birkenheuer et al., 2002). While the results of this study on the RNase P genes are not an identical and differentiated method for M. haemofelis and M. haemocanis, this study did not have enough data to determine HMs and classified into different species (do Nascimento et al., 2012). The studies frequently diagnosed HMs by using molecular assays and conventional PCR, which are more specific and sensitive than microscopic examination (Nibblett et al., 2010; Cetinkaya et al., 2016; Ravagnan et al., 2017), and the quantitative PCR method as real-time PCR was used to determine HMs copy numbers in the gene (Wengi et al., 2008; Ravagnan et al., 2017). The molecular assay was sensitive and more accurate than the microscopic diagnosis for blood parasites (Kawan, 2019). The molecular tests and phylogenetic analyses were used for detecting many tick-borne diseases in the blood of dogs from Iraq/Baghdad (Al-Obaidi et al., 2020; Badawi and Yousif, 2020a; Badawi and Yousif, 2020c; Badawi et al., 2022). Mycoplasma species needed special requirements for cultivation (Al-Safar and Al-Shammari, 1986); due to the inability to cultivate the HMs, real-time PCR methods and conventional PCR from blood samples were developed. The molecular assays are considered the gold standard method for the differentiation and detection of feline and canine HMs species (Willi et al., 2010). In the south region of Iran, the CMhp was fixed in dogs with intravascular hemolysis, but when compared, the Iranian CMhp isolate sequence under accession number KC762746 with the France isolate sequence (AY532390) showed the highest change in the nucleotides (Sharifiyazdi et al., 2014). The study aimed to detect infectious rates of hemotrophic Mycoplasma infections in dogs by molecular assay from Baghdad province for the first time and estimate the hematological values of infected and clinically healthy dogs. Material and methodsStudy period and locationThe present study was conducted from October 2023 to March 2024 at the College of Veterinary Medicine, University of Baghdad, on the dogs located in the different regions of Baghdad city. Animals and samples collectionThe study included 155 dogs of both sexes, 95 males and 60 females, different ages from 1 month to 10 years, and different breeds (including German shepherd (66), Malinois (29) crossbreed (22), huskies (12), terriers (18), Rottweilers (3), LoLo foxes (2), Pomeranian (2), and Pointer dog (1). All dogs were examined clinically and documented all data. The blood sample (2 ml) was taken from the cephalic vein of each dog and transferred to ethylene diamine tetra acetic acid for blood count by veterinary hemolyser, and blood smear by Giemsa staining for microscopic examination and deferential leukocyte count, then the blood was stored at −20 °C until molecular assay was conducted. DNA extractionThe DNA from 200 µl of blood was extracted using an extraction kit (Blood genomic extraction kit, Geneaid, Taiwan) according to the instructions of the manufacturer. The nanodrop apparatus (Thermo Fisher, USA) was used for measuring DNA concentration and purity. Finally, eluted DNA was stored at −20 °C until polymerase chain reaction. Polymerase chain reaction (PCR)The target gene for identified Hemotropic Mycoplasma in dogs was the 16s rRNA gene. In dogs, two primers were used to amplify a fragment of 618 bp of the target gene, F-HBT (ATA-CGG-CCC-ATA-TTC-CTA-CG) and R-HBT (TGC-TCC-ACC-ACT-TGT-TCA) (Criado-Fornelio et al., 2003). The total PCR reaction (25 µl) consisted of 12.5 µl of green master mix (Promega, USA), 1 µl of each forward and reverse primer (10 pmol), and 3 µl of template DNA, then added nuclease-free water to complete the volume of master mix to 25 µl and mixing by the vortex. The PCR thermo-cycles were as follows: initial denaturation 94 °C for 10 min (1 cycle), 40 cycles of denaturation 94 °C for 45 sec, annealing 55 °C for 45 sec, extension 72 °C for 45 sec, and final extension 72 °C for 7 min. The PCR amplicons were visualized by using 1.2% agarose gel with red-safe stain (ABM, Canda) under the blue light of the gel documentation system (ACCURIS/USA). Sequencing and phylogenetic treeThe nucleotide sequences of positive products of PCR of the 16s rRNA gene of the HMs were submitted to GenBank-16s rRNA (submit ncbi.n/m.nih.gov) and recorded under accession numbers PP903624.1, PP903625.1, PP903626.1, PP882836.1, PP882837.1, and PP882838.1. The nucleotide sequences of our isolates were aligned with the database available in the National Centre for Biotechnology Information (NCBI, BLAST, Nucleotide BLAST) of the same genus of the HMs in dogs. Also, the nucleotide database of high-similarity isolates was selected from NCBI for multiple sequence alignment. The evolutionary relationship of isolates was using the UPGMA method (Sneath and Sokal, 1973). The phylogenetic tree and evolutionary distances were achieved by using the maximum composite likelihood method and are in units of the number of base substitutions per site, MEGA6 software, to make the genetic relation of the isolates (Tamura et al., 2013). Statistical analysisThe studied parameters were performed by SPSS, version 20 for statistical analyses. Significant differences were evaluated by one-way ANOVA and odds ratio at level P< 0.05. Ethical approvalThe present study was approved by the Animal Care and Use Committee (ACUC) of the College of Veterinary Medicine/University of Baghdad (number piG-1291). ResultsThe diagnosis of hemotropic MycoplasmaThe microscopic diagnosis results by Giemsa stain showed chains of small cocci in the peripheral of the erythrocyte or chains of small dots in the middle of the erythrocyte (Fig. 1) and (Fig. 2). A total of 155 blood samples were examined for HMs by PCR technique that indicated a 595 bp–618 bp band of positive 16s rRNA gene of HMs (Fig. 3). Six out of 155 dogs tested were positive by PCR, producing a 4% infection rate of HMs in dogs in Baghdad/Iraq. Hematological changesThe hematological tests were conducted on 155 samples from dogs, including 30 clinically healthy dogs (10 females and 20 males, aged from 1 month to 9 years, and different breeds 6 Malinois, 19 German shepherds, and 5 Huskies). The blood of these 30 dogs was analyzed by PCR to confirm the negative results for HMs. The hematological parameters included RBC count. Hemoglobin concentration (Hb), hematocrit (HCT), MCV, MCH, MCHC, and red distribution widths (RDWs). While the leukocyte parameters included white blood cell (WBC) count and absolute differential leukocyte count.
Fig. 1. Hemotropic Mycoplasma in blood of dogs shows presences chains of cocci in the peripheral of RBC, thin smear with Giemsa stain :1000X.
Fig. 2. Hemotropic Mycoplasma in blood of dogs shows presences cocci as small dots in the middle of RBC, thin smear with Giemsa stain :1000X.
Fig. 3. Agarose gel electrophoresis 1.2% with red safe Stain. Lane 1–6: positive band (595 bp–618 bp) of 16S rRNA of Hemotropic Mycoplasma in dogs, M: DNA ladder, and Lane c: negative control. The results revealed that the mean of MCHC and RDWs of infected dogs were significantly lower (p < 0.05) than that of clinically healthy dogs (Table 1). The total and differential leukocyte counts of infected dogs were within the normal range with non-significant differences (Table 2). According to RBC indices results, two dogs out of six dogs with hemotropic mycoplasmosis exhibited normocytic normochromic anemia, while one dog exhibited microcytic normochromic anemia. Based on Hb and RBC values and clinical evaluation, three cases out of 6 (50%) with hemotropic mycoplasmosis are considered to have anemia. Clinical and physical examinationThe dogs that were diagnosed positive for hemotropic mycoplasmosis showed the following signs: heart arrhythmia (two dogs), severe emaciation (one dog), vomiting and weakness (one dogs), pale mucus membrane (three dogs), lethargy (onedog), and sitting on hind limbs (twodogs) (Fig. 4). Risk factors and epidemiologyRisk factors included age, sex, and breed. The results indicated a non-significantly higher risk of Hemotropic Mycoplasma infection in males (four males out of six dogs), with an odds ratio of 1.27, and a confidence interval of 95% (CI: 0.22–7.18). The probability of HMs infection was higher in the dogs older than 1 year (five dogs) when compared to the dogs younger than 1 year (one dog) (odds ratio 3.66, CI: 0.41–32.12, nonsignificant). Hemotropic Mycoplasma infections were more frequent and significantly higher in the Malinois dogs (five Malinois dogs out of six), with an odds ratio of 13.75 and CI: 1.52–123.7 when compared to only one German shepherd dog (Table 3). Phylogenetic analysisIn this study, the sequences of the 16S rRNA gene of HMs were available at the NCBI site, including three Candidatus Mycoplasma hematoparvum isolates (accession numbers PP903624.1, PP903625.1, and PP903626.1), while uncultured Mycoplasma species (accession numbers PP882836.1, PP882837.1, and PP882838.1) depended on sequence alignment with world sequences available in the NCBI, which had 100% identity to Mhc and uncultured Mycoplasma species. The phylogenetic tree of Candidatus Mycoplasma haematoparvum was constructed from 12 world isolates and three isolates of the present study. The analysis of the phylogenetic tree of the 16s rRNA gene of CMhp sequences in the current study was divided into two clusters (Fig. 5). Interestingly, the sequence of the second cluster (PP903626.1) was separately located from other world and Iraq isolates, while the first cluster showed that it did not present genetic diversity to isolates of Iran (MF419727.1), Turkey (MG594500.1), Thailand (KT359592.1), USA (KF366443.1), Italy (GQ129112.1), Cuba (MZ221181.1), Chile (K4117662.1), and Spain (GQ129114.1), with Iraqi isolates in the present study (PP903624.1 and PP903625.1). The GenBank recorded the sequences of the three isolates of the 16S rRNA gene under the name “uncultured Mycoplasma spp.” However, the sequence identities of these isolates are 100% to Mhc and uncultured Mycoplasma spp. The phylogenetic tree (Fig. 6) of the uncultured Mycoplasma spp. showed that all isolates (PP882836.1, PP882837.1, PP882838.1) in the present study clustered in the same clade (substitution per site 0.00007–0.00009) with Mhc from Japan (AB848714.1), South Korea (MN34534.1), Brazil (KP745857.1), Turkey (KY368749.1), and Mexico (MN294708.1), also with uncultured Mycoplasma spp. from Turkey (KX641905.1), Chile (MN164350.1), Japan (KX519723.1), Iran (KU886264.1), and others geographical regions (UK, Vietnam, Brazil, and Slovakia). Table 1. Erythrogram values of clinically healthy Hemotropic Mycoplasma in dogs; range and M ± SE.
Table 2. Leukogram values of clinically healthy, Hemotropic Mycoplasma infection in dogs; Range and M± SE.
Fig. 4. Severe emaciation and sitting on hind limbs in the female, Malinois dog, 7 years infected by Candidatus Mycoplasma haematoparvum. DiscussionThe current study used molecular results to demonstrate the infection rates of Hemotropic Mycoplasma in dogs of both sexes and different breeds and age groups in Baghdad city. The overall molecular infection rate of HMs species was 4%. The molecular assay showed that the infection rate was 2% of each CMhp and uncultured Mycoplasma spp., which had 100% matching with Mhc based on the 16S rRNA sequences. The infection rate in the present study was lower than in previous studies in dogs in south Iraq, which revealed that 45.8% were infected with Mhc (Radhi and Wadood Alsaad, 2022), 17.8% with Mhc and 7.02% with CMhp in Iran (Beus et al., 2024), 8.24% with Mhc, and 10.82% with CMhp in Turkey, and 14.3% with Mhc in Spain (Roura et al., 2010). However, the results in the present study were close to the low infection rate of some previous studies in dogs: 2.94% with Mhc and 0.59% with CMhp in Kyragyzstan (Altay et al., 2020), 5.3% with Mhc in Brazil (Soares et al., 2016), while the total infection rate of hemotropic mycoplasmosis in India was 2.75% out of 1235 dogs (Preena et al., 2020). The differences in the infection rates between different studies depend on sample size, types and population of animals, the healthy status of animals, and vector distribution, especially Rhipicephalus sanguineus tick. All these factors might influence the results (Barker et al., 2010; Roura et al., 2010). The highest infection rates were reported non-significantly in January in dogs older than 1 year, males, and significantly in the Malinois dogs; the non-significant association between these epidemiological risk factors and infection rate is due to statistical causes of the low number of positive cases of hemotropic Mycoplasma in dogs in some studies (Alves et al., 2014; Soares et al., 2016). The Malinois dogs in the present study are mainly used as police dogs. Moreover, these dogs showed that the living and surrounded conditions were casually associated with significant risk factors as vectors (Preena et al., 2020). Additionally, in some reports, male dogs were more susceptible to hemotropic mycoplasmosis than females (Barker et al., 2010; Willi et al., 2010). Different factors affect the epidemiology of hemotropic mycoplasmosis in dogs, such as environmental and geographical elements and transmission vectors (Zheng et al., 2017), host factors (Saxena and Srivastava, 2021), human practice (Liu et al., 2017), and the movement of dogs between regions without screening for hemotropic mycoplasmosis infections, which can trans the pathogen to new areas (Yüksel Dolgun and Kirkan, 2024). Investigating these epidemiological factors enables veterinary professionals to help manage and reduce the spread of this disease among dogs. The main hematological values exhibited significant changes in the MCHC, RDW, and PDWS; also, normocytic normochromic and microcytic normochromic anemia were observed in two dogs infected with hemotropic mycoplasmosis. The hematological changes may be different according to the stage of disease and physiological statues of dogs (Badawi and Yousif, 2020b; Qasim and Badawi, 2023); the anemia and leukocytosis developed during the acute stage of the disease. The anemia and leukocytosis developed during the acute stage of hemotropic mycoplasmosis (Soto et al., 2017; Jarad and Abed, 2020); although the prevalence of anemic dogs out of infected dogs was low (33.3%), the low MCHC in the hemotropic mycoplasmosis was also reported by (28). The hematological values related to erythrocytes and leukocytes indicate a non-significant change compared to the healthy group, while some studies indicate a significant decrease in RBCs, HCT, and hemoglobin with leukocytosis (Sharifiyazdi et al., 2014; Jarad and Abed, 2020; Radhi and Wadood Alsaad, 2022). Red cell distribution width (RDW) increased in the results in the infected dogs with hemotropic mycoplasmosis when compared to healthy groups; these changes indicate that RBC variation in size (Al-Kareem Qasim and Badawi, 2024), and high RDW is associated with certain conditions as hemolytic anemia (Berda-Haddad et al., 2017). The occurrence of hemolytic anemia or intravascular RBC hemolysis was confirmed in the hemotropic mycoplasmosis (Sharifiyazdi et al., 2014), and the hemotropic Mycoplasma pathogens have direct hemolytic effects on the RBC (Preena et al., 2020). A decrease in hematocrit can occur from various causes as blood loss due to bleeding, or parasites (like hookworms, Ehrlichia, Babesia, or fleas) (Saxena and Srivastava, 2021), decreased RBC production in inflammatory diseases, chronic kidney or liver diseases (Liu et al., 2017; Gwozdzinski et al., 2021). Table 3. The infection rate of Hemotropic Mycoplasma in dogs according to PCR is associated with age, sex, months, and breeds.
The phylogenetic analysis revealed that sequence alignment on the NCBI-BLAST site had a high identity (100%) with M. hacmocanis and candidatus Mycoplasma hemtoparvum. Alignment with several Mycoplasmas species based on the 16S rRNA gene revealed that three out of six isolated had 100% similarity to the Mhc and uncultured Mycoplasma spp. The NCBI recorded these three isolates under the name uncultured Mycoplasma spp. The relationship between geographical regions and isolates of the present study in the phylogenic trees revealed that sequences were grouped in the same branch of the several countries in the phylogenic tree, especially neighboring countries (Iran and Turkey). In the phylogenetic tree of uncultured Mycoplasma spp. of the present study, the turkey isolate (M. haemocanis Ky368749.1) sequences 100% identity with this Turkey isolate previously isolated from domestic dogs (Aktas and Ozubek, 2017). Furthermore, another turkey isolate (under the name uncultured Mycoplasma spp.) is in the same clade as the Iraq isolates with a high infection rate of 24%. This study indicated that the infection rates of hemotropic Mycoplasma species widely vary in different countries according to the presence of the vector and environmental conditions supporting the development of the vector (Guo et al., 2017). Also, uncultured Mycoplasma spp. Iranian isolate (KU886264.1) was clustered in our isolates in the phylogenetic tree; this isolate in dogs from southern Iran is also named M. haemocanis by researchers because of high identity 100% with M. haemocanis of other countries (Hasiri et al., 2016).
Fig. 5. Phylogenetic tree of partial sequences of the 16s rRNA gene of Candidatus Mycoplasma haematoparvum. Showing relationship between Iraq isolates and gene bank-related sequences from other countries. The blue triangles are CMhp isolates of current research.
Fig. 6. The phylogenetic tree displays partial sequences of the 16s rRNA gene from uncultured Mycoplasma spp. Showing relationship between Iraq isolates and gene bank-related sequences from other countries. The blue triangles are isolates of current research. The phylogenetic tree of CMhp includes sequences of other countries, especially neighboring countries Iran and Turkey. Two isolates of the current study were clustered in the same branch with isolates of neighboring countries, while one isolate was located in a single branch. Iran isolate (MF419727.1) was clustered with Iraq isolate and isolated from the blood of dogs in west Azerbaijan, Iran (unpublished). Also, in Turkey, isolate (MG594500.1) of CMhp was clustered and identical (100%) to two Iraq isolates; in Turkey, CMhp was found in one out of 100 dogs (Yüksel Dolgun and Kirkan, 2024). These results indicated that there was no specific substitution of sequences or genetic diversity of the hemotropic Mycoplasma in dogs based on geographic region or country. This study focused on HMs in dogs in Baghdad city and the first research on clinical, epidemiological, and hematological aspects of HMs in the dog population in Baghdad city. The focus on HMs is necessary to increase epidemiological knowledge, infection rate in dogs, and impact on dogs’ health in Baghdad city. Additionally, the lack of studies on these pathogens in other provinces of Iraq, except the Basra, combined with the growing of dog breeding in Iraq, especially in Baghdad. This study provides information for future investigations into HMs infections across other regions and animal populations. ConclusionThis study is the first molecularly and phylogenetically detected of hemotropic Mycoplasma in Baghdad/Iraq. The RBC hemolysis was confirmed in the hemotropic mycoplasmosis, and these pathogens have direct hemolytic effects on the RBC. This study indicated that the infection rates of hemotropic Mycoplasma species widely vary in different countries according to the presence of the vector and environment conditions. The results of phylogenetic analysis indicated that there was no specific substitution of sequences or genetic diversity of the hemotropic Mycoplasma in dogs from Iraq with other countries. The results concluded that the highest infection rates occurred in January in dogs older than 1 year, in male dogs, and in Malinois dogs. AcknowledgmentThe authors gratefully acknowledge all members of the College of Veterinary Medicine/University of Baghdad and staff members of the Veterinary Baghdad Hospital for supporting the current study. Conflict of interestThe authors have no conflict of interest to disclose. FundingNo funding was received. Authors’ contributionsDZS: Samples collections, hematological tests, and writing the manuscript. NMB: Molecular detection, phylogenetic analysis, statistical analysis, and reading and improving the final edition of the manuscript. Data availabilityAll data supporting the findings of this study are available within the manuscript. ReferencesAktas, M. and Ozubek, S. 2017. Molecular survey of haemoplasmas in shelter dogs and associations with Rhipicephalus sanguineus sensu lato. Med. Vet. Entomol. 31(4), 457–461. Al-Kareem Qasim, N.A. and Badawi, N.M. 2024. Assessment of haematological values and iron profile in dogs with iron deficiency, iron deficiency anaemia and anaemia without iron deficiency. Bulg. J. Vet. Med. 27(3), 1–12. Al-Obaidi, S.S.A., Al-Ani, J.M.K. and Al-Shammari, N.B. 2020. Molecular detection of some Anaplasma species in blood of dogs in Baghdad province, Iraq. Iraqi J. Vet. Med. 44(1), 39–45. Al-Safar, A.S. and Al-Shammari, A.J.N. 1986. Isolation of Mycoplasmas from equine in Baghdad area. Iraqi J. Vet. Med. 10(1), 91–102. Altay, K., Aydın, M.F., Aytmirzakizi, A., Jumakanova, Z., Cunusova, A. and Dumanlı, N. 2020. First molecular evidence for Mycoplasma haemocanis and Candidatus Mycoplasma haematoparvum in asymptomatic shelter dogs in Kyrgyzstan. Kafkas Univ. Vet. Fak. Derg. 26(1), 143–146. Alves, T.B., Faggion, S.A., Santos, E.V., Roberto, P.G., França, S.C., Fachin, A.L. and Marins, M. 2014. Real-time PCR-based study of haemotrophic Mycoplasmas in dogs from Ribeirão Preto, Brazil. Arch. Med. Vet. 46(2), 333–336. Arendt, M., Stadler, J., Ritzmann, M., Ade, J., Hoelzle, K. and Hoelzle, L.E. 2024. Hemotrophic Mycoplasmas—vector transmission in livestock. Microorganisms 12(7), 1278. Badawi, M., Qasim, M., Al-Graibawi, M., Khalaf, J. and Yousif A. 2022. First molecular detection and phylogenetic analysis of Ehrlichia canis in dogs from Baghdad, Iraq. Arch. Razi Inst. 77(6), 2431. Badawi, N.M. and Yousif, A.A. 2020a. Babesia canis spp. in dogs in Baghdad province, Iraq: first molecular identification and clinical and epidemiological study. Vet. World 13(3), 579. Badawi, N.M. and Yousif, A.A. 2020b. Estimation of some hematological and biochemical references values of clinically healthy dogs in Baghdad province, Iraq. Biochem. Cell. Arch. 20(2), 4931. Badawi, N.M. and Yousif, A.A. 2020c. Survey and molecular study of Babesia gibsoni in dogs of Baghdad province, Iraq. The Iraqi J. Vet. Med. 44(E0), 34–41. Barker, E.N. 2019. Update on feline hemoplasmosis. Vet. Clin. Small Anim. Pract. 49(4), 733–743. Barker, E.N., Tasker, S., Day, M.J., Warman, S.M., Woolley, K., Birtles, R., Georges, K.C., Ezeokoli, C.D., Newaj-Fyzul, A. and Campbell, M.D. 2010. Development and use of real-time PCR to detect and quantify Mycoplasma haemocanis and “Candidatus Mycoplasma haematoparvum” in dogs. Vet. Microbiol. 140(1–2), 167–170. Berda-Haddad, Y., Faure, C., Boubaya, M., Arpin, M., Cointe, S., Frankel, D., Lacroix, R. and Dignat-George, F. 2017. Increased mean corpuscular haemoglobin concentration: artefact or pathological condition? Int. J. Lab. Hematol. 39(1), 32–41. Beus, K., Goudarztalejerdi, A. and Sazmand, A. 2024. Molecular detection and identification of hemotropic Mycoplasma species in dogs and their ectoparasites in Iran. Sci. Rep. 14(1), 580. Birkenheuer, A.J., Breitschwerdt, E.B., Alleman, A.R. and Pitulle, C. 2002. Differentiation of Haemobartonella canis and Mycoplasma haemofelis on the basis of comparative analysis of gene sequences. Am. J. Vet. Res. 63(10), 1385–1388. Cetinkaya, H., Haktanir, D., Arun, S. and Vurusaner, C. 2016. Molecular detection and prevalence of feline hemotropic Mycoplasmas in Istanbul, Turkey. Acta Parasitol. 61, 165–171. Criado-Fornelio, A., Martinez-Marcos, A., Buling-Saraña, A. and Barba-Carretero, J.C. 2003. Presence of Mycoplasma haemofelis, Mycoplasma haemominutum and piroplasmids in cats from southern Europe: a molecular study. Vet. Microbiol. 93(4), 307–317. do Nascimento, N.C., Santos, A.P., Guimaraes, A.M.S., SanMiguel, P.J. and Messick, J.B. 2012. Mycoplasma haemocanis–the canine hemoplasma and its feline counterpart in the genomic era. Vet. Res. 43, 1–9. Erol, U., Altay, K., Ataş, A.D., Şahin, Ö.F. and Urhan, O.F. 2021. First molecular detection of canine hemoplasmas in Sivas province in central part of Turkey. Etlik Vet. Mikrobiyoloji Derg. 32(1), 27–32. Fadhil, A.I. 2014. Prevalence study of hard tick Rhipicephalus sanguineus in stray dogs from many areas from Baghdad province. Iraqi J. Vet. Med. 38(2), 9–11. Guo, H., Sevinc, F., Ceylan, O., Sevinc, M., Ince, E., Gao, Y., Moumouni, P.F.A., Liu, M., Efstratiou, A. and Wang, G. 2017. A PCR survey of vector-borne pathogens in different dog populations from Turkey. Acta Parasitol. 62(3), 533–540. Gwozdzinski, K., Pieniazek, A. and Gwozdzinski, L. 2021. Reactive oxygen species and their involvement in red blood cell damage in chronic kidney disease. Oxid. Med. Cell Longev. 2021(1), 6639199. Hasiri, M.A., Sharifiyazdi, H. and Moradi, T. 2016. Molecular detection and differentiation of canine hemoplasma infections using RFLP-PCR in dogs in southern Iran. Vet. Arhiv. 86(4), 529–540. Jarad, A. and Abed, F.A. 2020. Clinical and diagnostic studies of hemomycoplasmosis in dogs at Basrah, Iraq. Biochem. Cell. Arch. 20(2), 6171–6175 Kawan, M.H. 2019. Molecular surveillance and phylogenetic analysis of Theileria annulata in bovine at Baghdad city/Iraq. Iraqi J. Vet. Med. 43(1), 93–101. Liu, X., Liang, J., Qiu, Q., Teng, F. and Wang, Y. 2017. Association between hematocrit level and the development of non-alcoholic fatty liver disease in Chinese adults: a 5-year study. J. Metab. Synd. 6(220), 2167-0943. Mazaheri, N.F.R., Vahedi, S.M. and Mohammadkhan, F. 2014. Haemotropic Mycoplasmas (haemoplasmas): a review. Int. J. Adv. Biol. Biomed. Res. 2(5), 1484–1503. Nibblett, B.M.D., Waldner, C., Taylor, S.M., Jackson, M.L., Knorr, L.M. and Snead, E.C. 2010. Hemotropic Mycoplasma prevalence in shelter and client-owned cats in Saskatchewan and a comparison of polymerase chain reaction (PCR)—Results from two independent laboratories. Can. J. Vet. Res. 74(2), 91–96. Preena, P., Mohan, D., Sarangom, S.B., Sundaran, S., Santhosh, K., Ramesh Kumar, K.V. and Prasad, C.P. 2020. Prevalence of canine hemotrophic Mycoplasma in Kannur District of Kerala, India. Int. J. Curr. Microbiol. App. Sci. 9(7), 3668–3674. Qasim, N.A.A.-K. and Badawi, N.M. 2023. The haematological values and serum iron profile in dogs with some pathological and physiological conditions. J. Survey Fisher. Sci. 10(3S), 737–745. Radhi, A.S. and Wadood Alsaad, I.A. 2022. Clinical, biochemical and molecular study of Mycoplasma haemocanis in dogs in southern provinces of Iraq. Basrah J. Vet. Res. 21(S1), 44–57. Ravagnan, S., Carli, E., Piseddu, E., Da Rold, G., Porcellato, E., Zanardello, C., Carminato, A., Vascellari, M. and Capelli, G. 2017. Prevalence and molecular characterization of canine and feline hemotropic Mycoplasmas (hemoplasmas) in northern Italy. Parasit. Vectors 10(1), 132. Roblejo-Arias, L., Díaz-Sánchez, A.A., Corona-González, B., Meli, M.L., Fonseca-Rodríguez, O., Rodríguez-Mirabal, E., Marrero-Perera, R., Vega-Cañizares, E., Lobo-Rivero, E. and Hofmann-Lehmann, R. 2022. First molecular evidence of Mycoplasma haemocanis and ‘Candidatus Mycoplasma haematoparvum’ infections and its association with epidemiological factors in dogs from Cuba. Acta Trop. 228, 106320. Roura, X., Peters, I.R., Altet, L., Tabar, M.-D., Barker, E.N., Planellas, M., Helps, C.R., Francino, O., Shaw, S.E. and Tasker, S. 2010. Prevalence of hemotropic Mycoplasmas in healthy and unhealthy cats and dogs in Spain. J. Vet. Diagn. Invest. 22(2), 270–274. Saxena, H. and Srivastava, S. 2021. Review on complete blood count parameters of animals—a formidable aid in veterinary disease diagnosis. Acta Sci. Vet. Sci. 3(10), 80–96. Sharifiyazdi, H., Hasiri, M.A. and Amini, A.H. 2014. Intravascular hemolysis associated with Candidatus Mycoplasma hematoparvum in a non-splenectomized dog in the south region of Iran. Vet. Res. Forum 5(3), 243. Sneath, P.H.A. and Sokal, R.R. 1973. Numerical taxonomy: the principles and practice of numerical classification. San Francisco, CA: WF Freeman & Co., pp: 1–573. Soares, R.L., Echeverria, J.T., Pazzuti, G., Cleveland, H.P.K., Babo-Terra, V.J., Friozi, E. and Ramos, C.A. 2016. Occurrence of Mycoplasma haemocanis in dogs infested by ticks in Campo Grande, Mato Grosso do Sul, Brazil. Rev. Bras. Parasitol. Vet. 25(3), 360–363. Soto, F., Walker, R., Sepulveda, M., Bittencourt, P., Acosta-Jamett, G. and Müller, A. 2017. Occurrence of canine hemotropic Mycoplasmas in domestic dogs from urban and rural areas of the Valdivia province, southern Chile. Comp. Immunol. Microbiol. Infect. Dis. 50, 70–77. Tamura, K., Stecher, G., Peterson, D., Filipski, A. and Kumar, S. 2013. MEGA6: molecular evolutionary genetics analysis version 6.0. Mol. Biol. Evol. 30(12), 2725–2729. Wang, X., Cui, Y., Zhang, Y., Shi, K., Yan, Y., Jian, F., Zhang, L., Wang, R. and Ning, C. 2017. Molecular characterization of hemotropic Mycoplasmas (Mycoplasma ovis and ‘Candidatus Mycoplasma haemovis’) in sheep and goats in China. BMC Vet. Res. 13, 142. Wengi, N., Willi, B., Boretti, F.S., Cattori, V., Riond, B., Meli, M.L., Reusch, C.E., Lutz, H. and Hofmann-Lehmann, R. 2008. Real-time PCR-based prevalence study, infection follow-up and molecular characterization of canine hemotropic Mycoplasmas. Vet. Microbiol. 126(1–3), 132–141. Willi, B., Novacco, M., Meli, M.L., Wolf-Jäckel, G.A., Boretti, F.S., Wengi, N., Lutz, H. and Hofmann-Lehmann, R. 2010. Haemotropic Mycoplasmas of cats and dogs: transmission, diagnosis, prevalence and importance in Europe. Schweiz. Arch. Tierheilkd. 152(5), 237. Yüksel Dolgun, H.T. and Kirkan, Ş. 2024. The molecular detection of hemotropic Mycoplasma species in dogs. Thai J. Vet. Med. 53(2), 257–263. Zheng, W.Q., Chen, H.Y., Liu, M.M., Moumouni, P.F.A., Efstratiou, A., Liu, Z.B. and Xuan, X.N. 2017. First evidence of Mycoplasma haemocanis in China. Trop. Biomed. 34(4), 983–990. | ||
| How to Cite this Article |
| Pubmed Style Saeed DZ, Badawi NM. Molecular study and phylogenetic analysis of hemotropic Mycoplasma in Baghdad province, Iraq. Open Vet. J.. 2024; 14(12): 3417-3427. doi:10.5455/OVJ.2024.v14.i12.26 Web Style Saeed DZ, Badawi NM. Molecular study and phylogenetic analysis of hemotropic Mycoplasma in Baghdad province, Iraq. https://www.openveterinaryjournal.com/?mno=222543 [Access: June 26, 2026]. doi:10.5455/OVJ.2024.v14.i12.26 AMA (American Medical Association) Style Saeed DZ, Badawi NM. Molecular study and phylogenetic analysis of hemotropic Mycoplasma in Baghdad province, Iraq. Open Vet. J.. 2024; 14(12): 3417-3427. doi:10.5455/OVJ.2024.v14.i12.26 Vancouver/ICMJE Style Saeed DZ, Badawi NM. Molecular study and phylogenetic analysis of hemotropic Mycoplasma in Baghdad province, Iraq. Open Vet. J.. (2024), [cited June 26, 2026]; 14(12): 3417-3427. doi:10.5455/OVJ.2024.v14.i12.26 Harvard Style Saeed, D. Z. & Badawi, . N. M. (2024) Molecular study and phylogenetic analysis of hemotropic Mycoplasma in Baghdad province, Iraq. Open Vet. J., 14 (12), 3417-3427. doi:10.5455/OVJ.2024.v14.i12.26 Turabian Style Saeed, Dunya Zeyad, and Naseir Mohammed Badawi. 2024. Molecular study and phylogenetic analysis of hemotropic Mycoplasma in Baghdad province, Iraq. Open Veterinary Journal, 14 (12), 3417-3427. doi:10.5455/OVJ.2024.v14.i12.26 Chicago Style Saeed, Dunya Zeyad, and Naseir Mohammed Badawi. "Molecular study and phylogenetic analysis of hemotropic Mycoplasma in Baghdad province, Iraq." Open Veterinary Journal 14 (2024), 3417-3427. doi:10.5455/OVJ.2024.v14.i12.26 MLA (The Modern Language Association) Style Saeed, Dunya Zeyad, and Naseir Mohammed Badawi. "Molecular study and phylogenetic analysis of hemotropic Mycoplasma in Baghdad province, Iraq." Open Veterinary Journal 14.12 (2024), 3417-3427. Print. doi:10.5455/OVJ.2024.v14.i12.26 APA (American Psychological Association) Style Saeed, D. Z. & Badawi, . N. M. (2024) Molecular study and phylogenetic analysis of hemotropic Mycoplasma in Baghdad province, Iraq. Open Veterinary Journal, 14 (12), 3417-3427. doi:10.5455/OVJ.2024.v14.i12.26 |